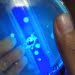
Mahasiswa Brawijaya Temukan Tinta Bercahaya dari Bakteri Laut

NEGARA Jepang dikenal sebagai pemakan ikan tuna terbesar di dunia. Jumlah hasil tangkapan tuna yang masuk ke Jepang, baik yang ditangkap sendiri dan yang dibeli dari luar jumlahnya mengalami fluktuasi dari tahun ke tahun.
Apalagi, hasil penelitian satu dekade lalu menyebutkan bila tidak ada pembatasan perburuan ikan tuna, pasokan dan persediaan akan berkurang. Bahkan tuna bisa musnah 30 tahun mendatang.
Kini penangkapan ikan tuna tidak semuanya langsung berasal dari perburuan di laut lepas. Sejumlah negara berupaya mengembangkan pemeliharaan tuna melalui budidaya. Seperti halnya di Jepang.
Berikut ini catatan Donna Octaviana, Penyuluh Perikanan Kabupaten Ogan Komering Ilir Provinsi Sumatera Selatan, di Motobu, Okinawa Jepang. Dona saat ini masih mengikuti Training Sustainable Fisheries Program dari Japan International Cooperation Agency.
Budidaya tuna di Jepang tidak dilakukan secara sembarangan. Dan tidak semua orang atau perusahaan bisa mendapatkan izin untuk membuka usaha budidaya ini. Misalnya, untuk budidaya bluefins tuna.
Hal ini lantaran jenis bluefins sudah dibatasi pengambilannya secara langsung dari alam.
Pemiliharaan tuna hasil budidaya ini rata-rata selama 2,5 tahun. Benih diambil dari alam, kemudian dibesarkan. Jumlah yang ditebar sebanyak 1.500 ekor.

Komentar tentang post